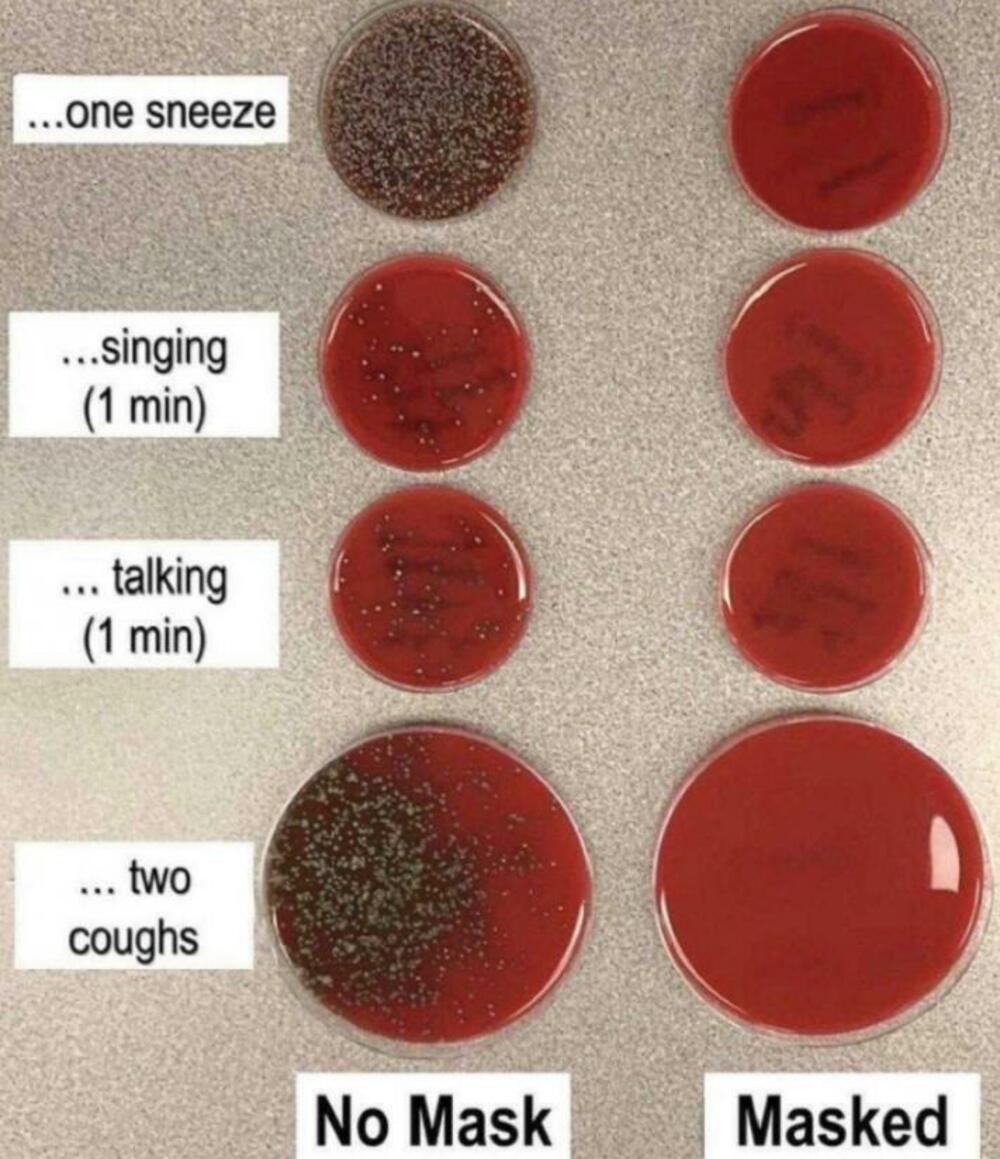
Maska

poznato
NAUČNIK POTVRDIO DA LI SU MASKE ZAISTA NEOPHODNE: Kada pročitate, uradićete samo 1 stvar
Pored vakcine, zaštitne maske zaista jesu najbolji način da se zaštitite od virusa, jer se korona najčešće prenosi na tri načina:
Jedna fotografija nedovsmisleno pokazuje koliko maske stvarno štite od bakterija i virusa.
Otkako je svet zadesila pandemija virusa korona, stručnjaci apeluju na nošenje zaštitnih maski. Zdravstveni radnici ne skidaju ih već duže od godinu i po dana, jer time štite i sebe i pacijente od širenja infekcije.
- Udisanjem vazduha u kojem ostaju male čestice virusa koje je "izbacila" zaražena osoba.
- Dospevanjem ovih čestica u oči, nos i usta.
- Dodirivanjem očiju, nosa ili usta rukama na kojima se nalaze čestice virusa.
Ono što mnogi ne znaju je da čestice zaraze mogu da se prenose kroz celu prostoriju (sobu, kuću, kancelariju, restoran...), a tu mogu da ostanu od nekoliko minuta do nekoliko sati.
Da biste izbegli kontakt sa česticama virusa, najvažnije je da nosite zaštitne maske, a kada vidite koliko one zaista štite, više nigde nećete ići bez njih.
Na Fejsbuk nalogu bolnice "Sveti Džozef" objavljena je fotografija koja nedvosmisleno pokazuje moć maski. Klinički mikrobiolog dr Ričard Dejvis iz bolnice Providens u Vašingtonu, sproveo je mali eksperiment kojim je pokazao koliko se bakterija proširi samo jednom kapljicom kada kine bez maske, a koliko kada nosi masku.
Takođe, testirao je količinu bakterija u kapljicama pljuvačke kada nosi i ne nosi masku dok jedan minut peva, isto toliko priča i kada se dvaput zakašlje.
Na osnovu toga i te kako se vidi koliko maske štite – nosite ih, zaštitite i sebe i druge!
(Espreso)
Uz Espreso aplikaciju nijedna druga vam neće trebati. Instalirajte i proverite zašto!












